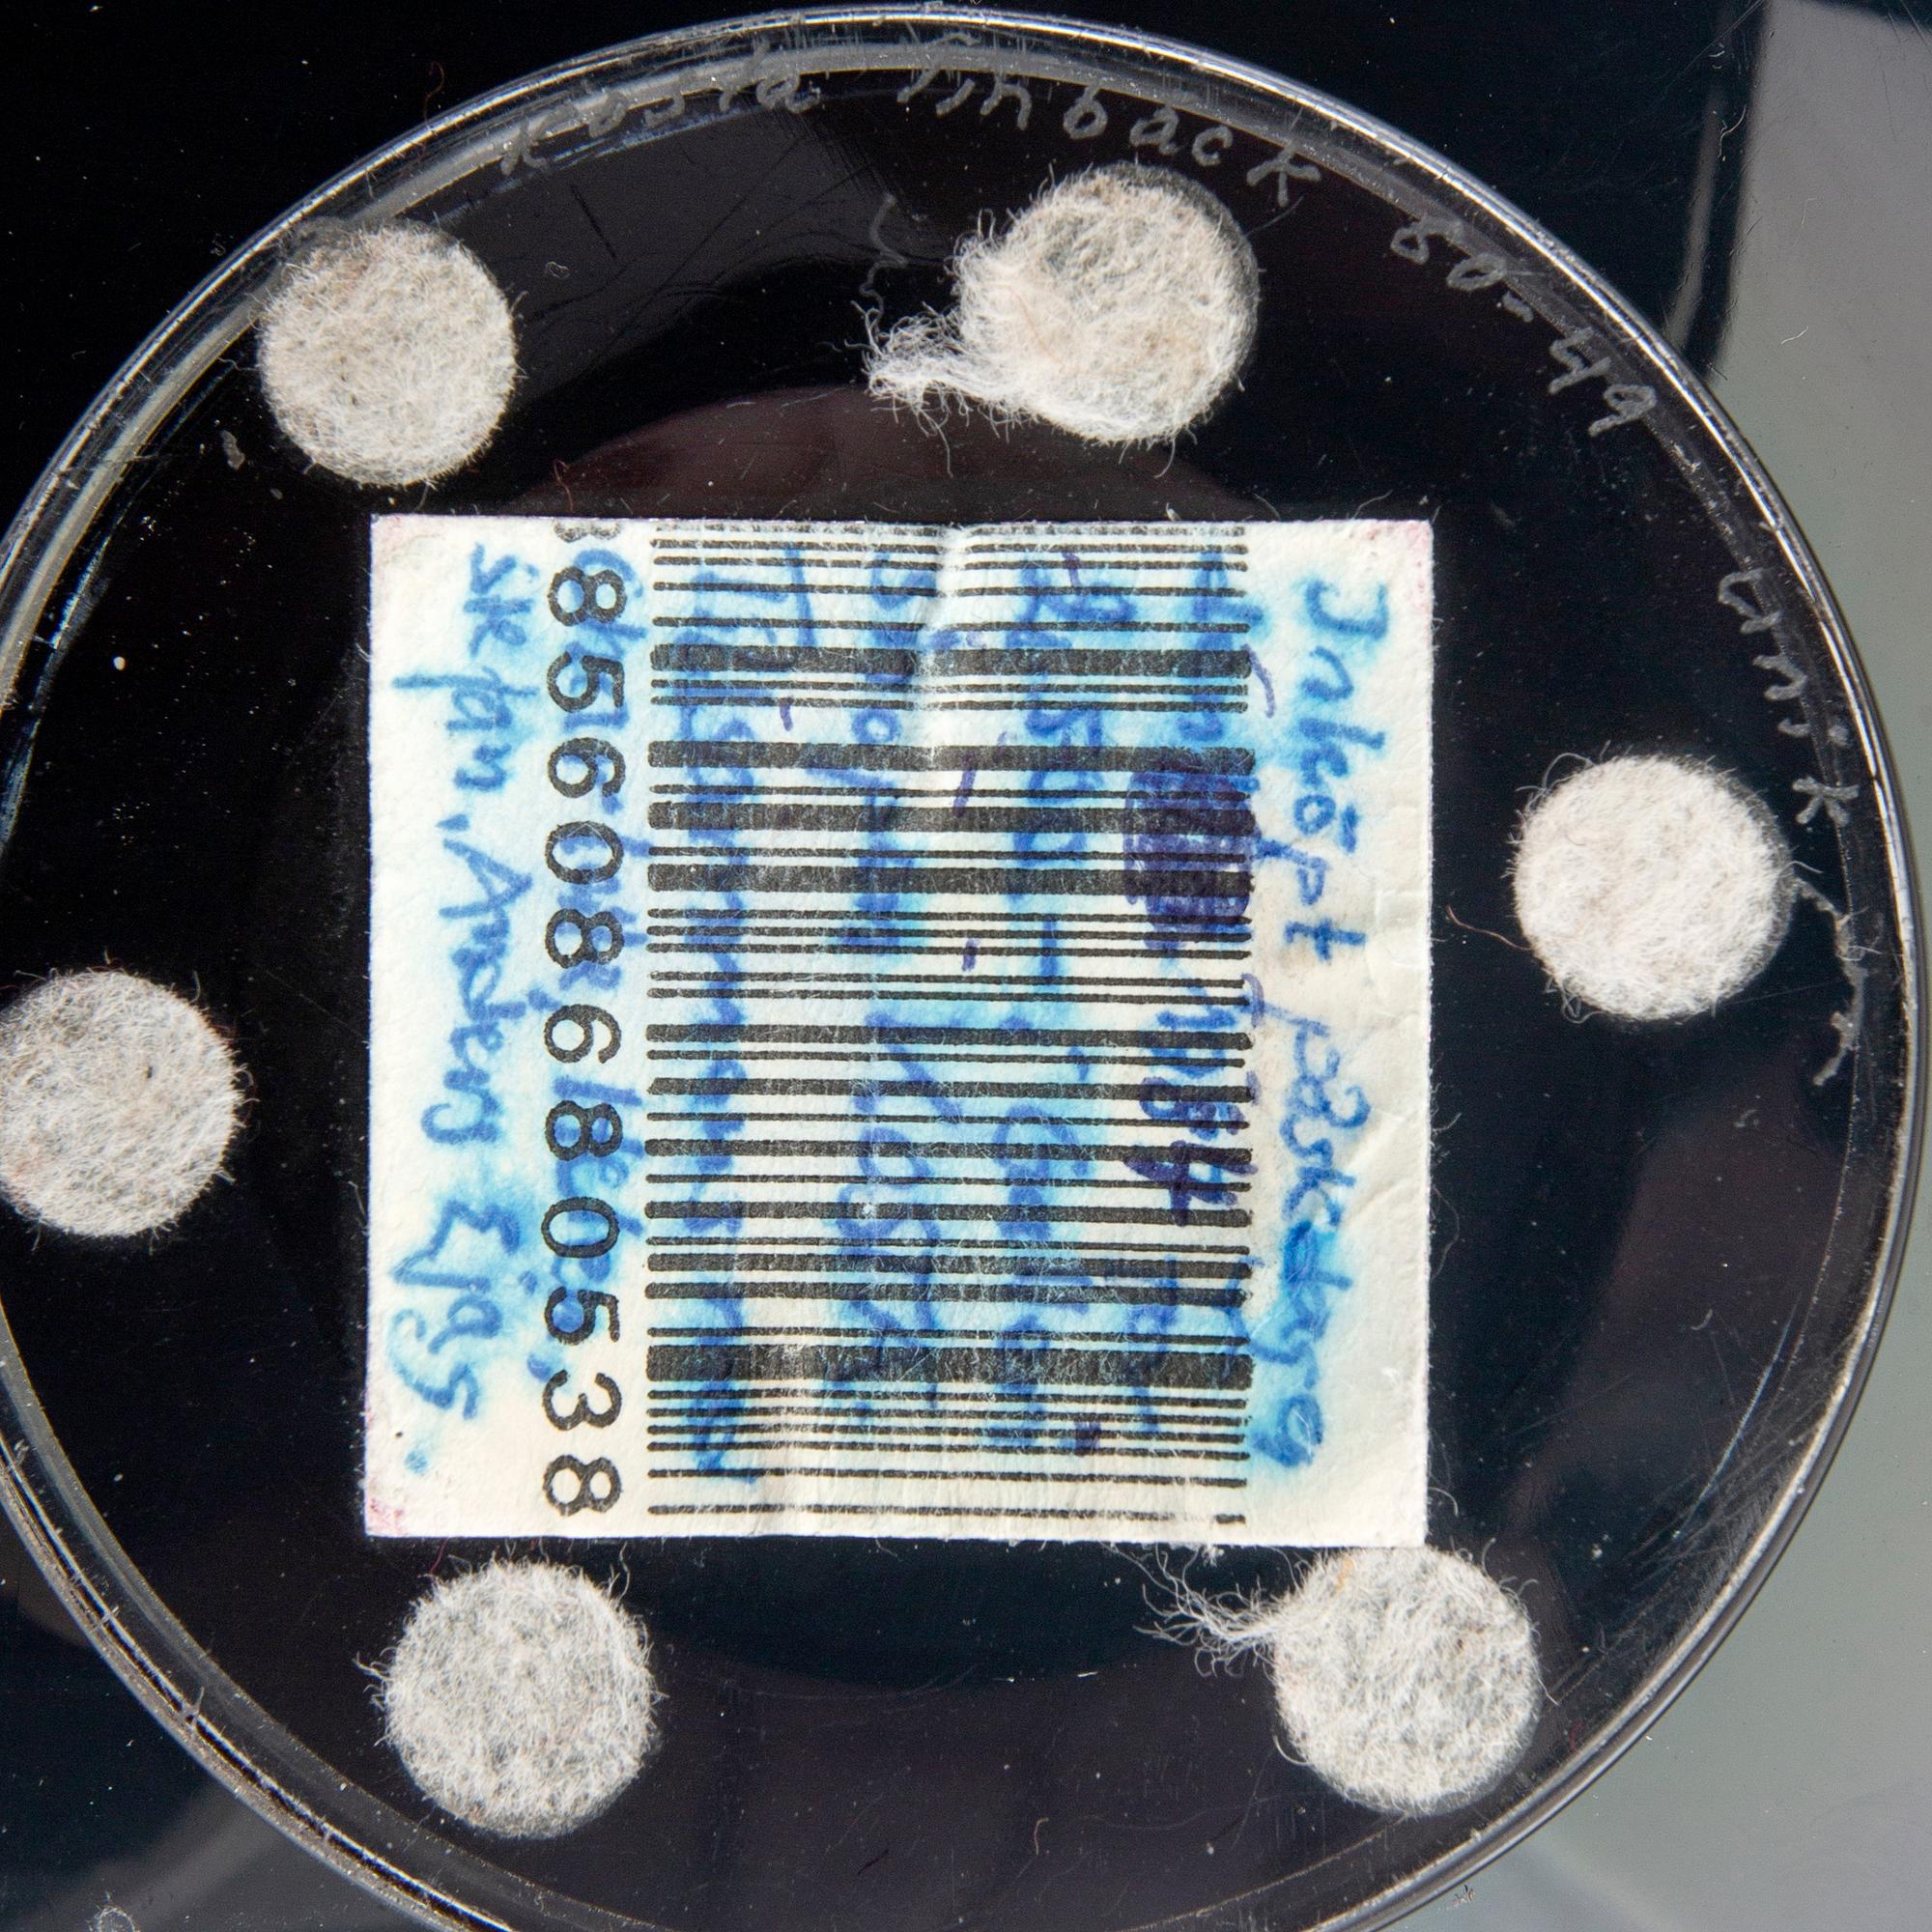
Klas-Göran Tinbäck,.

Klas-Göran Tinbäck(Ruotsi, Syntymävuosi 1951)
Klas-Göran Tinbäck,
Klas-Göran Tinbäck,
Signed Klas Göran Tinbäck 80-49 unique, cut decoration, diameter 31 cm, height 17 cm
Insignificant wear. Scratches. Manufacturing defects.
Ota yhteyttä
Asiakaspalvelu
Olethan yhteydessä asiakaspalveluumme, mikäli sinulla on kysymyksiä liittyen kuljetukseen, maksuun tai muihin asioihin.
Ruotsi
Puhelin maanantai – perjantai klo 9–12
+46 8-614 08 00
Suomi
Puhelin maanantai - perjantai klo 10–13
+358-9-668 91 10
Kuuluu jälleenmyyntikorvauksen piiriin
Tietoa ostamisesta
Kuvan käyttöoikeudet
Tämän tietokannan taideteokset ovat tekijänoikeudella suojattuja, eikä niitä saa kopioida ilman oikeudenhaltijoiden lupaa. Teokset kopioidaan tässä tietokannassa Bildupphovsrättin lisenssillä.
Muiden katsomia kohteita

1708528
Runar Engblom
Maljakko, signeerattu Runar Engblom Riihimäen Lasi Oy. 1940/50-luku.
Ei tarjouksia
6p 12 h
Lähtöhinta
250 EUR

1698351
Bertil Vallien
A unique sand cast glass wall sculpture "Idol".
Ei tarjouksia
4p 11 h
Lähtöhinta
8 000 SEK

1704955
Oiva Toikka
Three 'Paletti' glass cups, Nuutajärvi, Finland.
Ei tarjouksia
6p 12 h
Lähtöhinta
2 500 SEK

1696459
Letter weights,
3 pcs, second half of the 20th century.
Ei tarjouksia
2p 10 h
Lähtöhinta
1 500 SEK

1700443
Vicke Lindstrand
Göran Wärff, Caithness of Scotland, five glass paper weights, signed.
Ei tarjouksia
2p 10 h
Lähtöhinta
1 500 SEK

1704953
Timo Sarpaneva
Glass sculpture, "Claritas" signed Timo Sarpaneva Iittala 1984 C1767.
Ei tarjouksia
6p 11 h
Lähtöhinta
5 000 SEK

1700448
Six glass paperweights,
including Robert Eickholt, USA, 1985, & Caithness of Scotland.
Ei tarjouksia
2p 11 h
Lähtöhinta
1 500 SEK

1698353
Bertil Vallien
A unique sand cast glass wall sculpture "Idol".
Ei tarjouksia
4p 11 h
Lähtöhinta
8 000 SEK